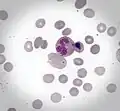
Cabot rings inside atypical erythrocyte. May-Grunwald staining (x400)

Cabot rings

B – Howell-Jolly body

Cabot rings are thin, red-violet staining, threadlike strands in the shape of a loop or figure-8 that are found on rare occasions in red blood cells (erythrocytes). They are believed to be microtubules that are remnants from a mitotic spindle, and their presence indicates an abnormality in the production of red blood cells.[1] Cabot Rings, considerably rare findings, when present are found in the cytoplasm of red blood cells and in most cases, are caused by defects of erythrocytic production[2] and are not commonly found in the blood circulating throughout the body.[3]
Cytologic appearance
Cabot rings appear as ring, figure-8 or loop-shaped structures on microscopy. Cabot rings stain red or purple with Wright's stain.
Associated conditions
Cabot rings have been observed in a handful of cases in patients with pernicious anemia, lead poisoning, certain other disorders of red blood cell production (erythropoiesis).[1]
History
They were first described in 1903 by American physician Richard Clarke Cabot (1868–1939).
Media
-
Cabot rings inside atypical erythrocyte. May-Grunwald staining (x400)
Cabot rings inside atypical erythrocyte. May-Grunwald staining (x400) -
 Nucleated red blood cell with Cabot rings and basophilic granules. May-Grunwald staining (x400)
Nucleated red blood cell with Cabot rings and basophilic granules. May-Grunwald staining (x400)
References
- ^ a b McPherson, Richard A; MR Pincus (2011). Henry's clinical diagnosis and management by laboratory methods (22nd ed.). Philadelphia, PA: Elsevier/Saunders. p. 526. ISBN 978-1437709742.
- ^ "Cabot Rings - LabCE.com, Laboratory Continuing Education". www.labce.com. Retrieved 2017-05-04.
- ^ "Cabot's Rings". www.chronolab.com. Archived from the original on 2018-05-14. Retrieved 2017-05-04.
Further reading
- Kass, L (July 1975). "Origin and composition of Cabot rings in pernicious anemia". American Journal of Clinical Pathology. 64 (1): 53–7. doi:10.1093/ajcp/64.1.53. PMID 1155375.
External links